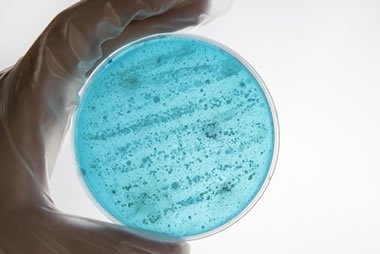

Routine Check Sparks Legionella Alert at Kennedy Tower, Royal Edinburgh Hospital
Edinburgh, September 2025 – A routine water quality inspection at Kennedy Tower, part of the Royal Edinburgh Hospital, Scotland, has uncovered Legionella bacteria in the building’s water systems. NHS Lothian has confirmed the findings and taken swift action.
The largely unoccupied tower has been closed, with the few remaining staff relocated as a precaution. Importantly, no patients were at risk, and the main psychiatric hospital remains fully operational and unaffected by the closure.
A version of this article first appeared in Legionella Control International’s newsletter. To get it in your inbox, sign up here.
The timing comes amid a worrying rise in Legionnaires’ disease across Scotland. Recorded cases have nearly quadrupled from just 16 in 2021 to 57 in 2024.
Though no illnesses have been reported in connection with Kennedy Tower yet, the discovery brings back memories of a serious 2012 outbreak in Edinburgh, where four people died and dozens were hospitalised after a Legionnaires’ outbreak, though the exact source was never identified.
What is Legionnaires’ Disease?
Legionnaires’ disease is a potentially fatal form of pneumonia caused by inhaling small droplets of water contaminated with Legionella bacteria. These bacteria thrive in complex water systems including hot and cold-water systems, cooling towers, and infrequently used plumbing, especially if water temperatures sit between 20 °C and 45 °C, and if systems are neglected or poorly maintained.
Symptoms of Legionnaires’ typically include:
- High fever and cough
- Respiratory infection
- Chest pain and flu-like aches
- In severe cases, pneumonia requiring hospital care.
While anyone exposed can fall ill, older adults, men, and those with weakened immune systems or chronic respiratory conditions are more at risk.
Preventing and Controlling Legionella . A Step-by-Step Approach
Drawing from Legionella Control International’s user-friendly framework, the following is a clear roadmap for controlling Legionella risks in buildings:
-
Identify Risks
- Conduct a comprehensive risk assessment of all water systems, including infrequently used sections.
- Look out for factors like water temperatures between 20–45 °C, aerosol generation, stagnation, and the presence of biofilm in the system… all of which promote environments conducive to bacterial growth.
-
Appoint a Competent Person
- Appoint a properly trained responsible person to oversee the Legionella assessment and control efforts.
- In larger or 24-hour operations, multiple trained individuals may be necessary to cover all shifts.
-
Prevent or Control the Risk
- Prevention is ideal, but where that’s not feasible, strict management controls must be applied.
- Remove or flush out inactive or little used pipework to avoid stagnation.
- Maintain safe water temperatures at all times. Above 50 °C for hot water and below 20 °C for cold which will inhibit bacterial growth.
-
Implement Practical Hygiene Measures
- Develop a written control plan detailing roles, schedules, cleaning, treatment, and monitoring procedures.
- Key controls include:
- Regular temperature monitoring
- Reducing mist or aerosol risks
- Cleaning to remove scale, debris, and biofilms
- Ensuring treatment chemicals or systems are effective.
-
Record Everything
- Keep detailed, written records of:
- Risk assessments
- Maintenance and treatment activities
- Temperature readings
- Training, responsibilities, and testing results.
-
Review Regularly
- The Legionella risk assessment should be reviewed at least every two years.
- Review the assessment more frequently if there are structural changes, increased bacterial detections, or documented cases of legionellosis.
And, of course, any confirmed cases of Legionnaires’ must be reported to health and safety authorities under RIDDOR and other legal regulations.
Lessons for the Future
- Vigilance in all areas matters. Even unused or under-occupied buildings like Kennedy Tower can become potential Legionella hotspots.
- Routine monitoring saves lives. Regular testing identified the problem early, avoiding patient exposure.
- Comprehensive water safety plans are essential; preparedness must not lapse in quiet corners of a facility.
- Rapid action is key. Prompt closure, relocation, and assessment helped contain the risk at the Kennedy Tower incident.
- Learn from the past. The 2012 Edinburgh outbreak demonstrates the importance of early detection and strong oversight to prevent repetition.
Conclusion
The Royal Edinburgh Hospitals Kennedy Tower incident may serve as a near miss, but by following systematic, practical steps as outlined by Legionella Control International, healthcare facilities and building managers can keep Legionella at bay. A well-constructed Water Safety Group led by an experienced Authorising Engineer (Water), following a robust Water Safety Plan … all executed vigilantly, remains our best safeguard against a costly and preventable danger.
Leading water safety specialists
Legionella Control International is a world leading water safety specialist, supporting those responsible for the control of Legionella and other waterborne pathogens in the workplace. Our expert water safety teams help keep water systems safe, protecting workplace health and safety.
If you are concerned by any of the issues raised here or you would like to speak with one of our water safety specialists, please call us today on 0330 223 36 86.


